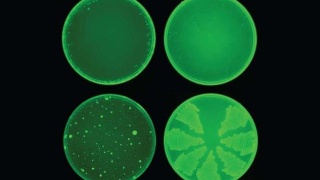

北京時(shí)間4月27日消息,據(jù)媒體報(bào)道,利用人工智能技術(shù)尋找毒品似乎取得了一定的回報(bào)。麻省理工學(xué)院的科學(xué)家透露,最新的人工智能技術(shù)發(fā)現(xiàn)了一種抗生素化合物哈利辛,它不僅能殺死多種形式的耐藥細(xì)菌,而且還能以一種新型的方式殺死它們。螺桿泵
許多抗生素在現(xiàn)有藥物的基礎(chǔ)上稍加改進(jìn),而halicin通過(guò)破壞細(xì)菌保持電化學(xué)梯度的能力來(lái)破壞細(xì)菌,而這種梯度是產(chǎn)生儲(chǔ)能分子所必需的,而儲(chǔ)能分子是細(xì)菌難以抵抗的。E、 在30天內(nèi),大腸桿菌對(duì)Halicin不產(chǎn)生任何耐藥性,并且它可以在3天內(nèi)擊敗更傳統(tǒng)的抗生素環(huán)丙沙星(cipofloxacin)。計(jì)量泵
該研究小組成功地開(kāi)發(fā)出一種比以往任何系統(tǒng)都能更有效地找到具有所需特性的分子結(jié)構(gòu)的系統(tǒng)。與以往的方法不同,人工智能神經(jīng)網(wǎng)絡(luò)可以自動(dòng)分析分子表征,并將其映射成連續(xù)的向量,以幫助預(yù)測(cè)其行為。一旦準(zhǔn)備好,研究人員將對(duì)2500種分子進(jìn)行人工智能培訓(xùn),包括:1700種已知藥物和800種天然產(chǎn)物。在研究6000種化合物的數(shù)據(jù)庫(kù)時(shí),人工智能發(fā)現(xiàn),halicin具有顯著的殺菌效果。離心泵
但是人們不應(yīng)該期望在短時(shí)間內(nèi)得到一個(gè)halicin的處方。麻省理工學(xué)院已經(jīng)成功地用這種藥物根除了老鼠身上的鮑曼爾桿菌(這是在阿富汗和伊拉克美國(guó)士兵中常見(jiàn)的感染)。人們更需要關(guān)注的是,這可能是一個(gè)新的更大趨勢(shì)的開(kāi)始??茖W(xué)家們利用自己的模型在另一個(gè)數(shù)據(jù)庫(kù)中篩選了超過(guò)1億個(gè)分子,發(fā)現(xiàn)了23個(gè)候選分子。排污泵
他們希望從零開(kāi)始設(shè)計(jì)抗生素,并修改現(xiàn)有藥物,以提高其有效性或減少其意想不到的副作用。這遠(yuǎn)不能保證消除“超級(jí)細(xì)菌”。然而,如果只有其中的一部分能夠被殺死,就能成功挽救許多生命。自吸排污泵